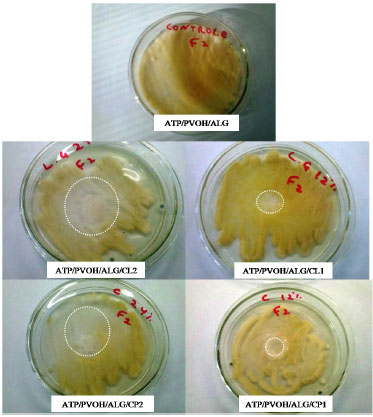

Artigo
|
|
| Microestrutura e propriedades de filmes de amido-álcool polivinílico-alginato adicionados de óleos essenciais de copaíba e capim limão The microstructure and properties of starch-polyvinyl alcohol-alginate films with copaiba and lemongrass oils |
|
Renata P. H. BrandeleroI,*; Fábio M. de AlmeidaI; Alexandre AlfaroII
IUniversidade Tecnológica Federal do Paraná, 85660-000 Dois Vizinhos - PR, Brasil Recebido em 08/01/2015 *e-mail: renatap@utfpr.edu.br Films obtained by blends between starch and other polymers and films developed with the addition of an oil can show higher water vapor barriers and improved mechanical properties. Films with starch/PVOH/alginate were obtained by adding copaiba and lemongrass essential oils (EOs). Films without oil served as the control. The microstructure, water vapor permeability (PVA), mechanical properties, and antifungal activity were determined for the films. The effects of the addition of the EOs on the properties of the films were dependent of the concentration and type of oil. The films with 0.5% lemongrass EO were similar to the control films. These films showed a 2.02 x 10-12 g s-1 Pa m-1 PVA, 11.43 MPa tensile stress, 13.23% elongation, and 247.95 MPa/mm resistance at perforation. The addition of 1% of copaiba EO increased the PVA from 0.5 x 10-12 to 12.1 x 10-12 g s-1 Pa m-1 and the diffusion coefficient from 0.17 x 10-8 to 7.15 x 10-8 m2/day. Films with quantities of EOs displayed fissures and micropores; the control films developed micropores with smaller diameters than films with EOs. The addition of EOs did not change the resulting infrared spectrum of the films. The films with oil displayed a diminished development of the Fusarium sp. culture, and the film without EOs did not display notable differences in the development of the culture. The starch/PVOH/alginate films with 0.5% lemongrass EO were the most suited for the development of a packaging active system. INTRODUÇÃO A elaboração de embalagens a partir de polímeros naturais como amido, gomas e proteínas encontra-se aliada às tendências ecológicas de produção de materiais, uma vez que os biopolímeros apresentam alta biodegradabilidade nas condições ambientais, são obtidos de fontes renováveis e apresentam baixos valores de comercialização comparados aos polímeros biodegradáveis sintéticos. Os filmes obtidos por biopolímeros podem compor um sistema de embalagens, ou serem adicionados em formulações contendo polímeros sintéticos ou bioengenheirados para diminuir custos e aumentar a disponibilidade dos materiais biodegradáveis para aplicações comerciais.1,2 Filmes de amido podem ser obtidos por casting, extrusão e em injetoras, resultando em materiais de baixa flexibilidade, permeáveis a água e de baixa permeabilidade ao oxigênio e ao dióxido de carbono, sendo as propriedades mecânicas geralmente inferiores às dos polímeros sintéticos. Segundo Yoshida e Antunes3 a aplicação de filmes obtidos por biopolímeros em embalagem para vegetais frescos, como frutas e hortaliças, reduz o amadurecimento, o escurecimento, a mudança de cor, a perda de aroma, pois promove uma barreira seletiva aos gases envolvidos nos processos respiratórios, diminuindo as taxas de metabolismo e oxidação. A principal limitação para aplicação destes filmes como embalagem se deve ao fato de que as propriedades mecânicas e a permeabilidade ao vapor de água (PVA) não são adequadas ou são alteradas conforme a umidade ambiente devido ao efeito plastificante da água. Muitas pesquisas estão sendo realizadas para reduzir a hidrofilicidade a partir de blendas entre amido e diferentes polímeros, pela adição de nanoargilas ou reforçadores como as fibras vegetais.4-6 Filmes de amido obtidos por blendas de amido e álcool polivinílico (PVOH) foram estudados por Faria e colaboradores2, que verificaram redução da PVA e melhora na resistência à tensão. O PVOH é um polímero biodegradável obtido pela remoção dos grupos acetatos do polivinilacetato, resultando em um polímero de álcool polivinílico parcial ou completamente substituído, o que resulta em diferentes graus de hidrólise. Misturas de amido com alginato foi estudada por Córdaba e colaboradores.7 Estes observaram que a presença de alginato aumentou a resistência mecânica e a elongação. Segundo os autores, o alginato de sódio está completamente hidratado nos filmes e nestas condições atua como um plastificante na presença de amido, aumentando o volume livre entre as cadeias de amilose. Brandelero e colaboradores8 estudaram as propriedades de filmes de amido de mandioca misturados com PVOH e/ou alginato. Os autores verificaram que filmes elaborados por blendas contendo os três polímeros foram menos hidrofílicos, mais flexíveis, mais resistentes à tensão e à perfuração e menos permeáveis ao vapor de água que filmes elaborados somente com amido ou com misturas de amido-PVOH ou amido-ALG. Os autores otimizaram as formulações por metodologia de mistura e apresentaram uma formulação contendo 80% de amido, 11,4% de ALG e 8,6% PVOH (massa/massa) como ótima para elaborar filmes com alto teor de amido com melhores propriedades mecânicas e permeabilidade ao vapor de água . A adição de óleos devido à característica hidrofóbica dos mesmos pode contribuir com a redução da hidrofilicidade dos filmes à base de polímeros hidrofílicos, uma vez que os óleos atuam como barreira à difusão do vapor de água na superfície do filme devido à formação de regiões mais apolares na matriz dos mesmos. Os óleos essenciais podem, além de apresentar o efeito relatado, contribuir para retardar a proliferação de microrganismos devido às suas propriedades antimicrobianas. 9-14 Brandelero e colaboradores10 verificaram que a adição de óleo de soja reduziu a permeabilidade ao vapor de água (PVA) e os valores da monocamada de filmes de amido/PBAT. Segundo os autores, a diminuição simultânea dos coeficientes de solubilidade e dos coeficientes de difusão foi responsável pelo efeito sobre a PVA. Resultados similares foram obtidos por Pellisari e colaboradores.13 Estes autores verificaram que filmes de amido/quitosana apresentaram diminuição significativa da PVA na presença de 1% de óleo de orégano, porém a adição do óleo resultou em prejuízos às propriedades mecânicas com diminuição da resistência à tensão. O óleo essencial de copaíba é extraído de árvores nativas da Amazônia Brasileira, sendo utilizado há séculos na medicina polular como antiflamatório, anti-séptico, antitumoral e no tratamento de doenças de pele e bronquite. Os bioativos presentes em maior quantidade no óleo são sesquiterpenos e diterpenos. O óleo de capim limão (Cymbopogon citratus) ou capim cidreira apresenta cerca de 70-80% da sua composição em citral. Segundo Balakrishnan,14 o óleo de capim limão apresenta efeito antibacteriano, antioxidante e inibe reações que podem alterar o DNA, sendo um fitoterápico sem efeitos tóxicos. O objetivo do presente trabalho foi avaliar o efeito da adição de óleo essencial de copaíba e capim limão nas propriedades físico-químicas e na microestrutura de filmes obtidos por blendas de amido/álcool polivinílico/alginato e a ação dos filmes com óleos essenciais no controle de Fusarium sp.
PARTE EXPERIMENTAL Material Os filmes foram preparados com amido de mandioca adquirido da Pinduca Alimentos (amido de mandioca PL, Araruna-PR, Brasil). O álcool polivinílico (PVOH) foi obtido da Sekisui Chemical Co. (E523) sob marca Sevol, grau de hidrólise 89%, viscosidade média. O alginato de sódio Algin I-3G, viscosidade média, foi adquirido da Kimica Corporation (Chile). O glicerol utilizado foi adquirido com grau comercial (Emfal, Brasil) com 98% de pureza. Os óleos essenciais de copaíba (Copaifera reticulada) e capim limão (Cymbopogon citratus) foram adquiridos da empresa Florananda Indústria e Comércio de Comésticos e Produtos Naturais LTDA (Brasil), ambos compostos declarados com 100% de óleo essencial extraídos de folhas de capim limão e do bálsamo obtido da Copaibeira. Produção dos filmes Os filmes foram produzidos pelo método de casting através da mistura ternária de amido termoplástico (ATP), álcool polivinílico (PVOH) e alginato de sódio (ALG). As proporções dos diferentes polímeros adicionadas na formulação destes filmes (ATP/PVOH/ALG) são dadas na Tabela 1.

Os filmes com misturas ternárias foram adicionados de 0, 0,5 e 1,0% de óleos essenciais de capim limão (OCL) e de copaíba (OCP) sobre a quantidade de solução filmogênica. Filmes com 100% de amido (ATP) sem adição de OE também foram obtidos. A quantidade total de polímero utilizada nas formulações foi igual a 4g/100 mL de solução. A quantidade de glicerol adicionada foi fixada em 20% sobre a massa total de polímeros. O amido foi gelatinizado na presença de glicerol sob agitação a 70 ºC por 45 minutos. Solução contendo PVOH + alginato (ALG) foi aquecida sob agitação a 80 ºC até a formação de uma solução viscosa e homogênea. A solução de amido+glicerol foi adicionada à solução de PVOH + ALG para produzir as blendas. Após a mistura das duas soluções, esta foi aquecida a 80 ºC sob agitação moderada por 15 minutos, obtendo-se a solução filmogênica. As proporções dos polímeros foram mantidas na solução filmogênica conforme definido na Tabela 1. As soluções filmogênicas ao atingirem a temperatura ambiente foram adicionadas de óleos essenciais nas quantidades de 1 ou 0,5 g/ 100 g da solução, filmes ternários (ATP/PVOH/ALG) sem adição de óleos serviram de controle. As soluções filmogênicas foram espalhadas em placas de acrílico (300 mm × 215 mm × 10 mm) na quantidade fixa de 15 mg de sólidos/cm2 da placa com finalidade de fixar a espessura (0,05 mm). As placas foram secas em estufa a 40 ºC por 14 horas. Permeabilidade ao vapor de água (PVA) A PVA dos filmes foi determinada conforme o método gravimétrico adaptado da normativa E 96-95 da ASTM15 (manteve-se o gradiente de umidade relativa (UR) em 73%). As umidades relativas (UR) empregadas foram de 2% (UR2) e 75% (UR1). A PVA foi calculada através da equação 1.  onde: TPVA é a taxa de permeabilidade ao vapor de água (g água/dia), δ é a espessura média dos filmes (m), A é a área de permeação da cápsula (28,26 × 10-4 m2), Ps é a pressão de saturação do vapor de água a 25 ºC (163.678,8) e UR é a umidade relativa no interior do dessecador (sub-índice 1) e no interior da cápsula (sub-índice 2). Isotermas de sorção As isotermas de sorção dos filmes foram determinadas em diferentes umidades relativas obtidas por soluções salinas saturadas (11,8%, 32,8%, 43,2%, 52,9%, 64,5 e 90%) a 25 ºC. Os corpos de prova de 2 × 2 cm foram cortados dos filmes e condicionados por 15 dias em dessecador com CaCl2. Os corpos de prova foram pesados e acondicionados em dessecador contendo soluções salinas até obter 3 pesos consecutivos iguais (equilíbrio). Após, os filmes foram secos em estufa a 105 ºC por 24 horas e pesados em balança analítica. A análise foi realizada em triplicata. As isotermas foram modeladas utilizando o modelo de GAB (Guggenhein-Anderson-de Boer) conforme a equação 2. O programa Statistica 6.0 foi utilizado para realizar a modelagem. Os parâmetros convergiram pelo método de Quasi-Newton.  onde: C (calor de sorção da monocamada), k (calor de sorção da multicamada) e mo (monocamada dada em g água/g sólidos) são os parâmetros do modelo, Xw é a umidade em base seca (g água/g sólidos) e aw é a UR/100. Determinação dos coeficientes de solubilidade (β) e de difusão (Dw) A metodologia utilizada para o cálculo do coeficiente de solubilidade (β) foi proposta por Larotonda e colaboradores,16 a partir da derivada de primeira ordem do modelo de GAB, que correlaciona a umidade em função da atividade de água dividida pela pressão de vapor de água (ps) na temperatura de 25 ºC, conforme a equação 3.  onde: β é o coeficiente de solubilidade e C, k e mo são os parâmetros do modelo de GAB, ps é a pressão de vapor de água a 25 ºC. O valor de aw utilizado foi a média do gradiente de UR/100. O coeficiente de difusão do vapor de água (Dw) foi determinado a partir dos valores de β e dos valores de PVA determinados para os filmes nas condições de umidade do item 2.3, utilizando a equação 4, sendo ρ a densidade dos filmes.  Análise das propriedades mecânicas As propriedades mecânicas avaliadas seguiram a normativa D 882 - 88 da ASTM.17 A resistência máxima à tração e a elongação foram analisadas usando um texturômetro Stable Micro System, modelo TA.TX2i (Inglaterra) do Laboratório de Química da UTFPR (Francisco Beltrão). As dimensões dos corpos de prova foram de 50 mm × 20 mm e foram condicionados até o equilíbrio na UR de 52,9%. Os corpos de prova foram colocados entre grampos pneumáticos, e a distância entre as garras foi de 50 mm e a velocidade de tração de 0,83 mm/min. Foram realizadas 4 determinações para cada amostra. A resistência à perfuração foi determinada em corpos de prova de 30 mm × 30 mm. Os valores de resistência foram expressos em Newton/mm, sendo os valores de perfuração divididos pela espessura dos filmes para padronizar o efeito da mesma na perfuração. Análise de infravermelho com transformada de Fourier (FT-IR) As amostras foram condicionadas por 15 dias em dessecador contendo CaCl2. Após, os filmes foram analisados pelo infravermelho utilizando espectrofotômetro Cary 630 - FT-IR Spectrometer-Agilent (Canadá) acoplado com dispositivo para leitura da refletância total atenuada equipado com cristal de diamante/ZnSe com tripla reflexão. A região espectral investigada foi de 4.000 a 400 cm-1, com resolução espectral de 4 cm-1. Análise da microestura por microscopia eletrônica de varredura As micrografias foram obtidas em microscópio eletrônico de varredura JEOL JSM-6360LV (USA) do Laboratório de Microscopia da Universidade Estadual de Campinas. Os filmes foram mantidos em dessecadores com CaCl2 por 15 dias. Após, foram fraturados em nitrogênio líquido. As fraturas foram fixadas em suportes de alumínio (stubs). Os stubs foram revestidos com uma camada de ouro/paládio. As amostras recobertas foram analisadas a 10 KeV. A magnitude da observação foi de 600-3.000x. Atividade antimicrobiana sobre culturas de Fusarium sp Foram coletadas amostras de frutos do mamoeiro contendo sintomatologia de contaminação por fungos. As amostras foram assepticamente diluídas em água peptonada. Cerca de 1 mL da amostra diluída foi colocada em placas de petri e pela técnica de pour plate foram cobertas com meio BDA (Merk, Brasil). As placas foram incubadas em estufa a 25 ºC por 15 dias. Após incubação um disco de 10 mm da cultura característica de Fusarium sp. foi transferido, sob condições assépticas, para placa de petri contendo meio BDA sólido. As placas foram incubadas a 25 ºC por 15 dias. A cultura foi identificada pelas suas características morfológicas como Fusarium sp. pelo Laboratório de Microbiologia da Universidade Tecnológica Federal do Paraná. Um inóculo (cerca de 108 UFC/g) da cultura identificada foi assepticamente transferida para placas contendo meios sólidos de BDA, e em condições assépticas os discos de 10 mm foram cortados dos filmes e colocados no centro das placas contendo Fusarium sp. As placas foram incubadas no escuro e após 3 dias uma área de inibição foi observada nas placas com filmes adicionados de óleos essenciais. O diâmetro da área observada foi determinado para diferenciar os tratamentos. Discos de filmes sem adição de óleo essencial foram incubados e serviram como controle (ATP/PVOH/ALG). Os testes foram realizados em duplicata.
RESULTADOS E DISCUSSÃO Isotermas de sorção As isotermas de sorção foram obtidas para os filmes formulados e estão apresentadas na Figura 1. As isotermas apresentaram comportamento do tipo II-III, característico de materiais sensíveis a água, sendo similares às isotermas obtidas por outros pesquisadores para filmes contendo amido.18-20 O modelo de GAB ajustou-se aos dados experimentais, os valores de monocamada (mo), constante de sorção (k) e calor de sorção (C) foram obtidos pelo método de Quasi-Newton a p=0,05. Os parâmetros do Modelo de GAB estão apresentados na Tabela 2.
 Figura 1. Isotermas de sorção dos filmes elaborados obtidas a 25º C para filmes ternários de ATP/PVOH/ALG com OE e sem adição de OE de capim limão e copaíba

O valor de monocamada (mo) foi o parâmetro mais importante para explicar a influência das formulações na hidrofilicidade dos filmes. Os valores do parâmetro C não foram significativos para todas as isotermas a p=0,05 e os valores de k não apresentaram uma tendência com a formulação. Filmes com 100% de amido apresentaram monocamada (mo) igual a 10,05 g água/100g sólidos e filmes ternários sem óleo essencial (OE) (ATP/PVOH/ALG) apresentaram mo igual a 6,77 g água/100 g de sólidos. Estes resultados indicam que filmes elaborados com mistura de amido+PVOH+alginato foram menos hidrofílicos que os elaborados somente com amido. Brandelero e colaboradores8 estudaram filmes elaborados com amido/PVOH/ALG e verificaram que o efeito ocorre pela formação de interações químicas entre os polímeros, reduzindo a disponibilidade dos sítios ativos para ligação com a água na matriz do filme. Observa-se que os filmes adicionados de OE apresentaram menor água de sorção que filmes com 100% de amido e filmes controle (ATP/PVOH/ALG) em toda a faixa de URE estudada. Os valores de mo encontrados para filmes adicionados de OE variaram de 6,56 - 4,36 g água/100 g de sólidos conforme a concentração e com o tipo de óleo, indicando que a adição de OE reduziu a hidrofilicidade dos filmes. Filmes com maior concentração de OE de copaíba (1%) apresentaram os menores valores para a monocamada (mo), embora a análise das isotermas de sorção sugira que filmes com 1% de OE de capim limão apresentaram menor quantidade de água de sorção em condições de UR menor que 80%. Os valores da constante C aumentaram para filmes com adição de OE de copaíba, exceto para filmes com 1% de OE de capim limão. Este parâmetro relaciona a energia de interação entre as moléculas de água e a matriz do filme. Assim, filmes mais hidrofílicos tem maior facilidade de realizar tais interações, ou seja, a energia requerida para a água estabelecer interações é menor nestes filmes. Os filmes com 1% de OE de copaíba apresentaram menor valor de mo e maiores valores de C, indicando que entre os filmes formulados foram os menos hidrofílicos. O comportamento apresentado para as isotermas de sorção dos filmes adicionados de OE obtidos neste trabalho foi similar aos publicados por Sánchez-González e colaboradores,21 que avaliaram as isotermas de filmes de hidroximetilcelulose com adição de óleo essencial de Tea Tree na concentração de 0,5-2%. Estes autores verificaram que o OE reduziu a capacidade de ganho de água dos filmes formulados. O efeito dos OE segundo os autores ocorre em fases separadas, ou seja, não há interação do OE com a matriz do filme. Os resultados obtidos pela análise de infravermelho (Figura 2) dos filmes elaborados confirmam que não houve interação dos OE com os polímeros que formam a matriz dos filmes. A adição de OE criou regiões mais lipofílicas na matriz dos filmes, aumentando o efeito de barreira à passagem do vapor de água devido à falta de afinidade pela água nestas regiões.
 Figura 2. Espectros no infravermelho obtido para os filmes ternários de ATP/PVOH/ALG com OE e sem adição de OE de capim limão e copaíba
Permeabilidade ao vapor de água (PVA), coeficiente de solubilidade (β) e coeficiente de difusão (Dw) A espessura dos filmes foi determinada e está apresentada na Tabela 3. Observa-se que embora os valores de espessura tenham sido diferentes do valor fixado (0,005 mm), as diferenças de espessura entre os tratamentos não foram significativas (p>0,05), indicando que os mesmos podem ser comparados entre si.

Os valores de PVA, do coeficiente de solubilidade (β) e do coeficiente de difusão (Dw) foram determinados e estão apresentados na Tabela 3. Verifica-se que os filmes de ATP/PVOH/ALG sem adição de óleo essencial (filme controle) foram os menos permeáveis e apresentaram menor coeficiente de difusão para a água (Dw), embora não tenham diferido dos filmes com 100% de amido e dos filmes com 0,5% de OE. Os filmes adicionados de 1% de OE foram mais permeáveis que o filmes adicionados com 0,5% do óleo. Observando os valores apresentados na Tabela 3, verifica-se que com o aumento da concentração de OE houve redução na solubilidade dos vapores de água (valores de β) na matriz dos filmes e aumento da permeação do vapor de água por difusão (valores de Dw). Os resultados indicam que a concentração de 1% de OE prejudicou a integridade estrutural dos filmes. As micrografias (Figura 3) obtidas para os filmes indicam que o aumento da concentração de OE propiciou poros e fissuras maiores na matriz dos filmes, confirmando o comportamento apresentado pelos valores de Dw que foram maiores para os filmes com óleo.
 Figura 3. Micrografias das fraturas dos filmes ATP/PVOH/ALG -600x sem adição de óleo com aumento de 600x e ATP/PVOH/ALG -3300x com aumento de 3300 vezes, com adição de 0,5 ou 1% de OE de copaíba (ATP/PVOH/ALG/CP1 e ATP/PVOH/ALG/CP2) e com adição de 0,5 ou 1,0% de OE de capim limão (ATP/PVOH/ALG/LG1 e ATP/PVOH/ALG/LG2)

Os filmes com 1% de OE de copaíba, embora tenham apresentado os menores valores de monocamada (Tabela 2), foram os mais permeáveis a água, indicando que a PVA dos filmes depende da relação entre os valores de β e de Dw. O efeito apresentado se deve ao fato de que a PVA é controlada por dois processos distintos, sendo o primeiro a solubilização do vapor na superfície do filme que depende da afinidade química da água pela matriz do filme, e o segundo por processos de difusão que estão relacionados com a integridade estrutural dos mesmos.19 Os filmes com 100% de amido apresentaram valores de PVA igual a 2,36 × 10-12 g s-1 Pa m-1. Estes valores foram menores que os determinados por outros autores.19,22 A permeabilidade ao vapor de água (PVA) dos filmes obtidos pela mistura ternária de ATP/PVOH/ALG (5,0 × 10-13 g s-1 Pa m-1) foi menor que a determinada para filmes com 100% de amido, embora a diferença não tenha sido significativa (p>0,05), e similares aos determinados por Krochta e colaboradores23 para os filmes de polietileno de baixa densidade (0,05 mm), que foi igual a 9,5 × 10-13 g s-1 Pa m-1, indicando que os filmes ternários obtidos apresentaram baixa permeabilidade aos vapores de água na condição na qual foram avaliados. Propriedades mecânicas Filmes de ATP/PVOH/ALG sem adição de óleo apresentaram valores similares para a resistência máxima à tensão (p>0,05) aos filmes produzidos somente com amido, porém foram mais elásticos e mais resistentes à perfuração que os filmes elaborados somente com amido. O comportamento observado foi similar ao determinado por Brandelero e colaboradores.10 Filmes de ATP/PVOH/ALG quando adicionados de óleos essenciais apresentaram alterações nas propriedades mecânicas conforme a concentração do óleo. A adição de 1% de óleo de copaíba diminuiu a resistência dos filmes de 8,11 MPa para 1,77 MPa, a elongação de 13,03% para 7,87% e a resistência à perfuração de 384,45 N/mm para 107,98 N/mm, sendo os filmes com menor eficiência quanto ao comportamento mecânico. Filmes de ATP/PVOH/ALG adicionados de 1% de OE de capim limão apresentaram propriedades mecânicas similares (p<0,05) aos filmes controle (ATP/PVOH/ALG). A diminuição da resistência à tração e aumento na elongação em filmes de amido e quitosana adicionados de OE de orégano foi observada por Pelissari e colaboradores,13 o que ocorre devido ao efeito plastificante do óleo. No presente trabalho a adição de OE na concentração de 1% reduziu a resistência e a elongação, indicando que o efeito se deve ao prejuízo estrutural dos filmes na presença de óleos, o que pode ser confirmado pelas micrografias (Figura 3). A adição de OE resulta em uma matriz descontínua com porosidade e cavidades maiores que as apresentadas pelos filmes controle. Filmes com menor concentração de OE de capim limão apresentaram comportamento mecânico similar aos filmes sem óleo (ATP/PVOH/ALG), exceto para a resistência à perfuração, sendo a adição de até 0,5% considerada compatível com a integridade física dos filmes. Os filmes obtidos neste trabalho apresentaram resistência à tração variando entre 1,77-11,91 MPa, e foram considerados apropriados para aplicações como embalagens em concordância com Pelissari e colaboradores,13 que determinaram valores de resistência para filmes de amido/quitosana com ou sem OE entre 1,43-2,54 MPa e consideraram os filmes capazes de resistir ao transporte e manipulação dos alimentos. Espectros dos filmes no infravermelho Os espectros no infravermelho foram obtidos para filmes de ATP/PVOH/ALG com ou sem óleo essencial e estão apresentados na Figura 2. Os espectros obtidos foram similares aos obtidos por Brandelero e colaboradores8 para filmes de amido/PVOH/ALG. Estes autores verificaram que filmes com 100% de amido diferiram dos espectros dos filmes de amido/PVOH/ALG na intensidade das bandas, principalmente, na banda larga que aparece entre 3300 e 3000 que corresponde aos estiramentos dos grupos OH, indicando que filmes ternários apresentam uma redução nas hidroxilas livres entre cadeias de polímeros. Filmes de ATP/PVOH/ALG com e sem óleos essenciais não apresentaram alterações na intensidade e na posição de picos e bandas, indicando que não houve interações químicas entre os óleos essenciais e a matriz do filme. O resultado obtido indica que a mistura entre OE e os polímeros da blenda não compromete o efeito dos bioativos presentes no óleo de copaíba e de capim limão. Comportamento similar foi verificado por Maizura e colaboradores24 em filmes de amido-alginato adicionados de óleo essencial de lemongrass. Segundo os autores o resultado evidencia que o bioativo não interagiu com os polímeros da matriz do filme, conservando a ação esperada do OE. Os resultados sobre a cultura de Fusarium sp confirmam o comportamento apresentado, uma vez que o halo de inibição da cultura aumentou com a concentração do OE, evidenciando que os óleos estão livres para atuarem sobre os microrganismos (Tabela 5).

Microscopia As micrografias foram obtidas para os filmes de ATP/PVOH/ALG com e sem óleo essencial e estão apresentadas na Figura 3. Filmes com e sem óleos essenciais apresentaram microporos ao longo da matriz. Este efeito ocorre porque filmes obtidos por casting são produzidos pela evaporação contínua da água que ao atravessar a matriz dos filmes cria as microestruturas observadas. Nos filmes sem adição de OE verifica-se maior quantidade de microporos que nos filmes com adição de 0,5% OEs. No entanto, conforme escala das micrografias, observa-se nos filmes com OEs, principalmente nos com 1% de OEs, poros ou fissuras, com diâmetro aproximado a 20 µm, enquanto nos filmes sem OE os microporos apresentaram diâmetro aproximado de 5 µm (Figura 3-ATP/PVOH/ALG-3330x), ou seja, 4 vezes menores. Filmes adicionados de 1% de OE apresentaram maiores valores do coeficiente de difusão e permeabilidade ao vapor de água que filmes sem OE. O comportamento destas propriedades, provavelmente, está associando à estrutura microscópica dos filmes. O efeito do óleo no aumento do diâmetro das cavidades e fissuras ocasionou, provavelmente, maior prejuízo à integridade estrutural dos filmes, o que facilitou a passagem do vapor de água. A presença dos OE na matriz do filme, provavelmente, selecionou as regiões mais polares para passagem do vapor de água, o que pode ter aumentado o diâmetro dos poros. Sánchez-González e colaboradores21 obtiveram microscopias semelhantes às apresentadas no presente trabalho. Estes autores elaboraram filmes de hidroximetilcelulose adicionados de óleo essencial de tea tree pelo método de casting e verificaram porosidades nos filmes sem óleo que aumentaram de tamanho com a presença e com a concentração do óleo, e o efeito também foi relacionado com o processo de secagem dos filmes. Atividade antimicrobiana sobre culturas de Fusarium sp. Os filmes foram avaliados quanto à atividade antifúgica. Uma cultura de Fusarium sp. foi utilizada para verificar o efeito. Observou-se que placas que receberam filmes com óleo apresentaram menor desenvolvimento microbiano em relação aos filmes sem adição de óleo. O diâmetro da área circular traçada na região onde a cultura foi visivelmente inibida foi determinado, os resultados então apresentados na Tabela 5. O aspecto visual das placas após incubadas com a cultura e com os filmes está apresentado na Figura 4. A placa que recebeu filme sem óleo essencial (Figura 4 - ATP/PVOH/ALG) foi considerada como referência. As placas que receberam filmes com óleos essenciais apresentaram regiões de inibição para a cultura de Fusarium sp. Nesta região traçou-se um círculo e o diâmetro deste círculo foi determinado para diferenciar os tratamentos. Observe que não foi possível obter halos de inibição com diâmetro perfeito, no entanto, considerou-se o maior diâmetro da área de inibição como adequado para diferenciar os tratamentos.
Figura 4. Aspectos das placas com Fusarium sp. inoculadas com filmes sem óleo essencial (ATP/PVOH/ALG) e inoculadas com OE de copaíba (ATP/PVOH/ALG/CP1 e ATP/PVOH/ALG/CP2) ou OE de capim limão (ATP/PVOH/ALG/LG1 e ATP/PVOH/ALG/LG2)
O tamanho do diâmetro da área de inibição aumentou conforme a concentração dos OEs, indicando que o efeito é dependente da concentração dos mesmos (Figura 4). Filmes sem adição de óleos essenciais não apresentaram efeito sobre o desenvolvimento da cultura (Figura 4- ATP/PVOH/ALG), confirmando que o efeito observado se deve à adição dos bioativos presentes na composição dos óleos essenciais. Os filmes com OE de capim limão apresentaram maior diâmetro, ou seja, maior área de inibição (Figura 4 - ATP/PVOH/ALG/CL2) para a cultura de Fusarium sp. em comparação ao OE de copaíba (Figura 4 - ATP/PVOH/ALG/CP2), o que está relacionado com a composição característica de cada óleo. O óleo de copaíba apresenta terpenos em sua composição, como o cariofileno, enquanto o óleo de capim limão apresenta fenóis como o citral, sendo que ambos os bioativos apresentam na literatura ação sobre o fungo avaliado. O óleo essencial de capim limão é apontado como eficaz para o controle de espécies de Fusarium sp. e outros fungos pós-colheita em várias pesquisas,25-27 sendo que para conservação de sementes a concentração do OE foi limitada uma vez que interfere na germinação das mesmas,25 configurando como uma área para estudos dos filmes obtidos, uma vez que o óleo imobilizado na embalagem deve apresentar menor efeito na germinação das sementes. Verifica-se que o desenvolvimento da cultura foi influenciado, principalmente, quando filmes com 1% de OE de capim limão foram incubados.
CONCLUSÃO A adição de óleos essenciais provocou alterações nas propriedades de barreira e mecânicas dos filmes. O efeito foi dependente da concentração e da natureza do óleo essencial. A adição de óleo essencial de capim limão na concentração de 0,5% não prejudicou as propriedades dos filmes. Filmes adicionados de OE de copaíba foram mais permeáveis a agua e menos resistentes. As substâncias que compõem os OE analisados não interagiram com a matriz do filme como demostram os espectros no infravermelho, indicando que os OE podem ser liberados para atuar como antimicrobianos. Filmes adicionados de OE inibiram o desenvolvimento de uma cultura de Fusarium sp., indicando que os bioativos adicionados foram liberados da matriz dos filmes. Os filmes com óleo essencial de capim limão foram os mais bioativos para controle dos microrganismos. Os filmes ternários obtidos com 0,5% de OE de capim limão foram considerados apropriados para aplicação como embalagens ativas ou na composição de filmes multicamadas com finalidade de controle do desenvolvimento de patógenos como Fusarium sp.
AGRADECIMENTOS Agradecemos à Fundação Araucária pela concessão de bolsa de iniciação científica.
REFERÊNCIAS 1. Franchetti, S. M. M.; Marconato, J. C; Quim. Nova 2006, 29, 811. DOI: http://dx.doi.org/10.1590/S0100-40422006000400031 2. Faria, F. de O.; Vercelheze, A. E. S.; Mali, S.; Quim. Nova 2012, 35, 487. DOI: http://dx.doi.org/10.1590/S0100-40422012000300009 3. Yoshida, C. M. P.; Antunes, A. J.; Ciênc. Tecnol. Aliment. 2009, 29, 420. DOI: http://dx.doi.org/10.1590/S0101-20612009000200030 4. Mali, S.; Grossmann, M. V. E.; Yamashita, F.; Semina: Ciências Agrárias 2010, 31, 137. 5. Brito, G. F.; Agrawal, P.; Araújo, E. M.; Mélo, T. J. A.; Revista Eletrônica de Materiais e Processo 2011, 6, 127. 6. Rodrígues, M.; Osés, J.; Ziani, K.; Maté, J. I.; Food Res. Int. 2006, 39, 840. DOI: http://dx.doi.org/10.1016/j.foodres.2006.04.002 7. Córdoba, A.; Cuéllar, N.; Gonzáles, M.; Medina, J; Carbohydr. Polym. 2008, 73, 409. DOI: http://dx.doi.org/10.1016/j.carbpol.2007.12.007 8. Brandelero, R. P. H; Yamashita, F.; Zanela, J.; Brandelero, E. M.; Caetano, G. J.; Starch/Staerke, 2015, 67, 191. DOI: http://dx.doi.org/10.1002/star.201400119 9. The, D. P.; Debeaufort, F.; Voilley, A.; Luu, D.; Food Hydrocolloids 2009, 23, 691. DOI: http://dx.doi.org/10.1016/j.foodhyd.2008.05.006 10. Brandelero, R. P. H.; Grossmann, M. V.; Yamashita, F.; Polímeros 2013, 23, 270. 11. Brandelero, R. P. H; Grossmann, M. V. E. Yamashita, F.; Carbohydr. Polym. 2012, 90, 1452. DOI: http://dx.doi.org/10.1016/j.carbpol.2012.07.015 PMID: 22944402 12. Maizura, M; Fazilah, A.; Norziah, M. H.; Karim, A. A.; J. Food Sci 2007, 72, C324. DOI: http://dx.doi.org/10.1111/j.1750-3841.2007.00427.x PMID: 17995673 13. Pelissari, F. M.; Grossmann, M. V. G; Yamashita, F. Pineda, E. A. G.; J. Agric. Food Chem. 2009, 57, 7499. DOI: http://dx.doi.org/10.1021/jf9002363 PMID: 19627142 14. Balakrishnan, B.; Paramasivam, S.; Arulkumar, A.; Asian Pac. J. Trop. Dis. 2014, 4, S134. DOI: http://dx.doi.org/10.1016/S2222-1808(14)60428-X 15. ASTM - American Society for Testing and Materials - E 96-95. Annual Book of ASTM Standards, ASTM : Philadelphia,1995. 16. Larotonda, F. D. S.; Matsui, K. N.; Sobral, P. J. A.; Laurindo, J. B.; J. Food Eng. 2005, 71, 394. DOI: http://dx.doi.org/10.1016/j.jfoodeng.2004.11.002 17. ASTM - American Society for Testing and Materials - D882-88. Annual Book of ASTM Standards, ASTM: Philadelphia, 1995. 18. Mali, S.; Grossmann, M. V. E.; Garcia, M. A. G; Martino, M. N; Zaritzky, N. E.; Carbohydr. Polym. 2002, 50, 379. DOI: http://dx.doi.org/10.1016/S0144-8617(02)00058-9 19. Bertuzzi, M. A.; Vidaurre, E. F. C.; Armada, M.; Gottifredi, J. C.; J. Food Eng. 2007, 80, 977. 20. Perdomo, J.; Cova, A.; Sandoval, A. J.; García, L.; Laredo, E.; Müller, A. J.; Carbohydr. Polym. 2009, 76, 305. DOI: http://dx.doi.org/10.1016/j.carbpol.2008.10.023 21. Sánchez-González, L.; González-Martínez, C.; Chiralt, A.; Cháfer, M.; J. Food Eng. 2010 , 98, 443. DOI: http://dx.doi.org/10.1016/j.jfoodeng.2010.01.026 22. Müller, M. O.; Yamashita, F; Laurindo, J. B.; Carbohydr. Polym. 2008, 72, 82. DOI: http://dx.doi.org/10.1016/j.carbpol.2007.07.026 23. Krochta, J. M.; De Mulder-Johnston, C.; Food Technol. 1997, 51, 61. 24. Maizura, M.; Fazilah, A.; Norziah, M. H.; Karim, A. A.; J.Food Sci. 2007, 72, C324. DOI: http://dx.doi.org/10.1111/j.1750-3841.2007.00427.x PMID: 17995673 25. Velluti, A.; Sanchis, V.; Ramos, A. J.; Egido, J.; Marin, S.; Int. J. Food Microbiol. 2003, 89, 145. DOI: http://dx.doi.org/10.1016/S0168-1605(03)00116-8 PMID: 14623380 26. Tzortzakis, N. G.; Economakis, C. D.; Innovative Food Sci. Emerging Technol. 2007, 8, 253. DOI: http://dx.doi.org/10.1016/j.ifset.2007.01.002 27. Pawar, V. C.; Thaker, V. S.; World J. Microbiol. Biotechnol. 2007, 23, 1099. DOI: http://dx.doi.org/10.1007/s11274-006-9339-6 |
On-line version ISSN 1678-7064 Printed version ISSN 0100-4042
Qu�mica Nova
Publica��es da Sociedade Brasileira de Qu�mica
Caixa Postal: 26037
05513-970 S�o Paulo - SP
Tel/Fax: +55.11.3032.2299/+55.11.3814.3602
Free access





